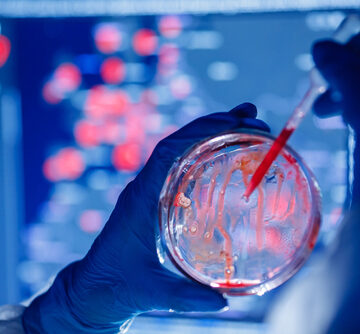
AI FINDS A DRUG TO KILL A DRUG-RESISTANT BACTERIUM

We have become a nation in a permanent state of emergency.
Power-hungry and lawless, the government has weaponized one national crisis after another in order to expand its powers and justify all manner of government tyranny in the so-called name of national security.